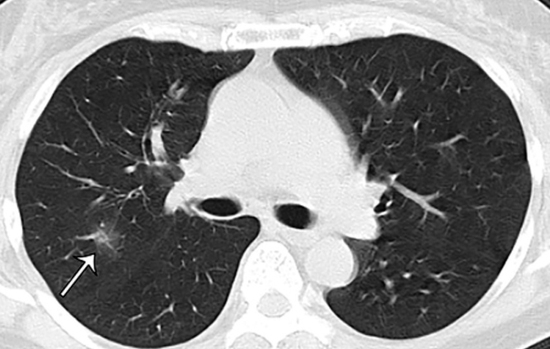

Коварный COVID-19: вы можете и не знать, что болели, но ваши легкие будут поражены!
Фото: pubs.rsna.org
У переболевших коронавирусом без симптомов обнаружены поражения легких - об этом говорится в исследовании японских ученых, которые проанализировали состояние 104 заразившихся COVID-19 пассажиров лайнера Diamond Princess.
Японцы изучали результаты компьютерной томографии.
Из 104 пассажиров "Бриллиантовой принцессы" 76 человек (73%) перенесли коронавирус без симптомов.
И у больше, чем половины - 41 человека из этих "бессимптомных" по результатам КТ обнаружились изменения в легких (так называемый "эффект матового стекла").
Кстати, в другой части группы самыми распространенными симптомами стали кашель (20%), температура (11%) и общая слабость (10% случаев).
Если верить японским ученым, получается, что даже бессимптомное течение коронавирусной болезни не проходит бесследно для ее носителей.
Заметили ошибку? Пожалуйста, выделите её и нажмите Ctrl+Enter








